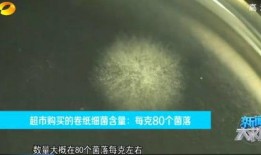
卫生纸新闻爆料,揭秘新闻爆料背后的真相

-
娱乐吃瓜酱陪伴是最长情,最长情的娱乐瓜果时光
亲爱的读者们,你是否也有过这样的时刻:在忙碌的生活中,突然想要放松找点乐子?那就跟着我一起,来一场说走就走的“娱乐吃瓜之旅”吧!...
2025-09-15 22 -
安徽萧县爆料新闻事件,惊现疑似违规操作事件引发社会关注
最近安徽萧县发生了一件让人瞠目结舌的新闻事件,真是让人忍不住想要一探究竟。听说这件事在网络上引起了不小的轰动,那我们就来一起揭开...
2025-09-15 23 -
郭航爆料离婚了吗视频,视频揭露婚姻破裂内幕
最近娱乐圈可是热闹非凡呢!郭航这个名字,相信很多人都不陌生吧。这位曾经的明星夫妻,最近可是引起了不小的关注。那么,郭航爆料离婚了...
2025-09-14 30 -
吃瓜娱乐ship,揭秘娱乐圈背后的故事与真相
亲爱的读者们,你是不是也和我一样,每天忙碌之余,总想找点乐子呢?没错,说的就是我最近迷上的“吃瓜娱乐”风潮。这不,今天就来和你聊...
2025-09-14 25 -
卫生纸新闻爆料,揭秘新闻爆料背后的真相
最近网上可是炸开了锅,关于卫生纸的新闻爆料,简直让人瞠目结舌!你有没有想过,我们每天离不开的卫生纸,竟然隐藏着这么多秘密?今天,...
2025-09-12 23 -
吃瓜小子表情包下载免费,免费下载,轻松逗乐你的朋友圈
你有没有发现,最近网上流行起了一个超级搞笑的表情包——“吃瓜小子”?这个表情包简直太逗了,每次看到都忍不住笑出声来。今天,我就要...
2025-09-11 21 -
高密医生爆料最新消息,最新医疗事件背后惊人真相
你知道吗?最近高密的一位医生可是爆出了大消息,这消息一出,整个医疗界都炸开了锅!这位医生可是行内的大咖,他的话,那可是有分量的。...
2025-09-11 24 -
旅鼠在线观看,在线探索神秘动物世界的奇幻之旅
你有没有想过,在这个信息爆炸的时代,连旅鼠的冒险故事都能通过网络与你亲密接触呢?没错,就是那些在北极圈里跳来跳去的可爱小家伙们,...
2025-09-11 24 -
叙事类的视频更容易爆料吗,如何成为爆料利器
你有没有发现,最近在各种社交媒体上,那些叙事类的视频好像特别容易爆火呢?是不是觉得这种现象很神奇?今天,我们就来聊聊这个话题,看...
2025-09-11 25 -
王者大批皮肤爆料视频,海量爆料视频带你领略英雄风采
最近有没有被王者荣耀的新皮肤爆料视频刷屏啊?没错,就是那个让无数玩家心动的王者大批皮肤爆料视频!今天,就让我带你一起深入了解一下...
2025-09-11 22